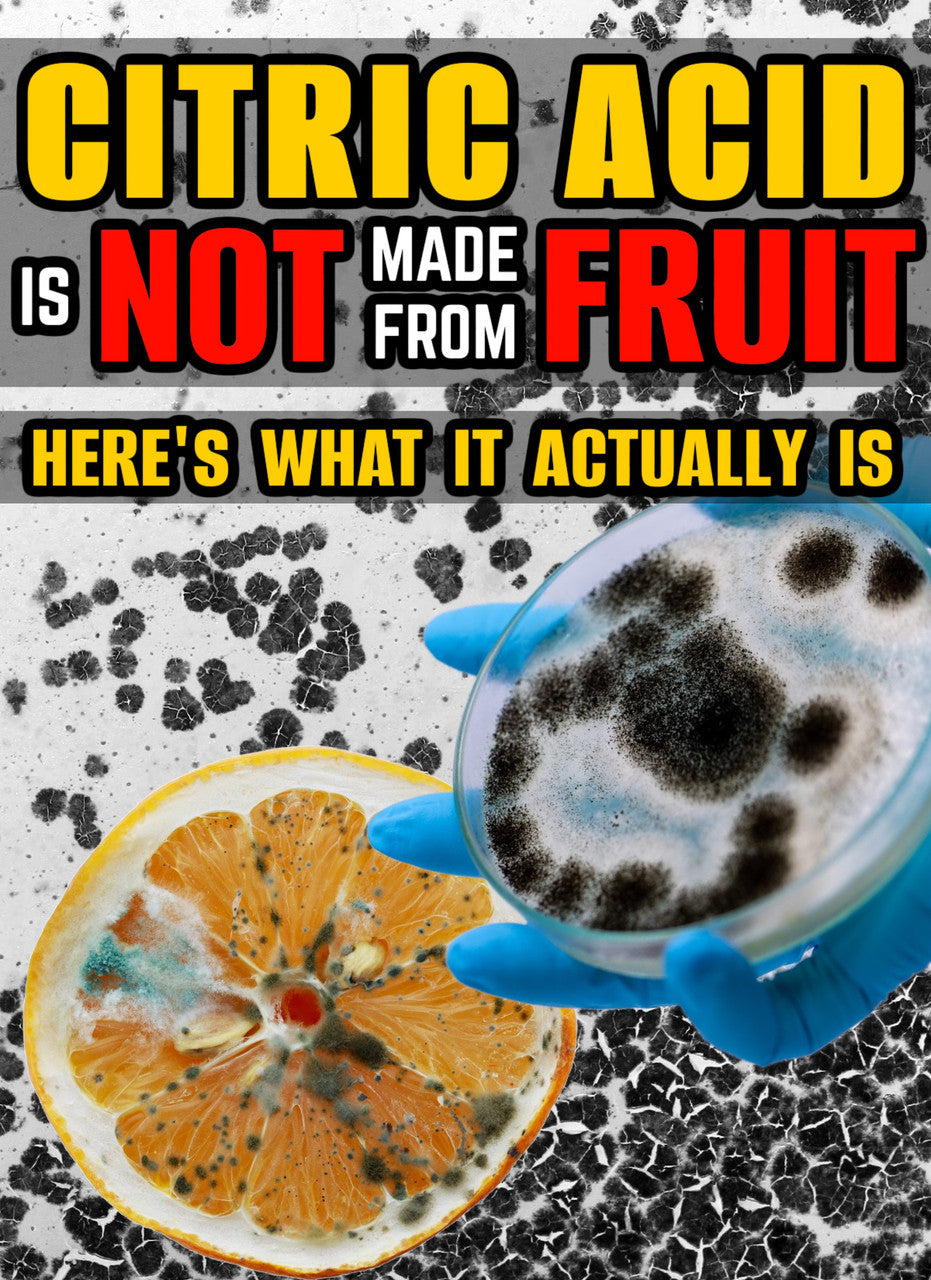

Citric Acid is NOT Made from Fruit! Here's What it ACTUALLY is! (eBook by Agent131711)
Citric Acid is NOT Made from Fruit! Here's What it ACTUALLY is! (eBook by Agent131711)
23 Pages, Written by Agent131711. Learn what Citric Acid ACTUALLY is - trust me, it's not what you think! And you never would have guessed what it actually is!
This awesome eBook is only $1.99! If you would like to donate to our cause of raising awareness and providing historic documents that shatter the narrative, you are welcome to pay what you feel we deserve. Every penny goes toward fighting the good fight by exposing Truth.
Couldn't load pickup availability
Your payment information is processed securely. We do not store credit card details nor have access to your credit card information.